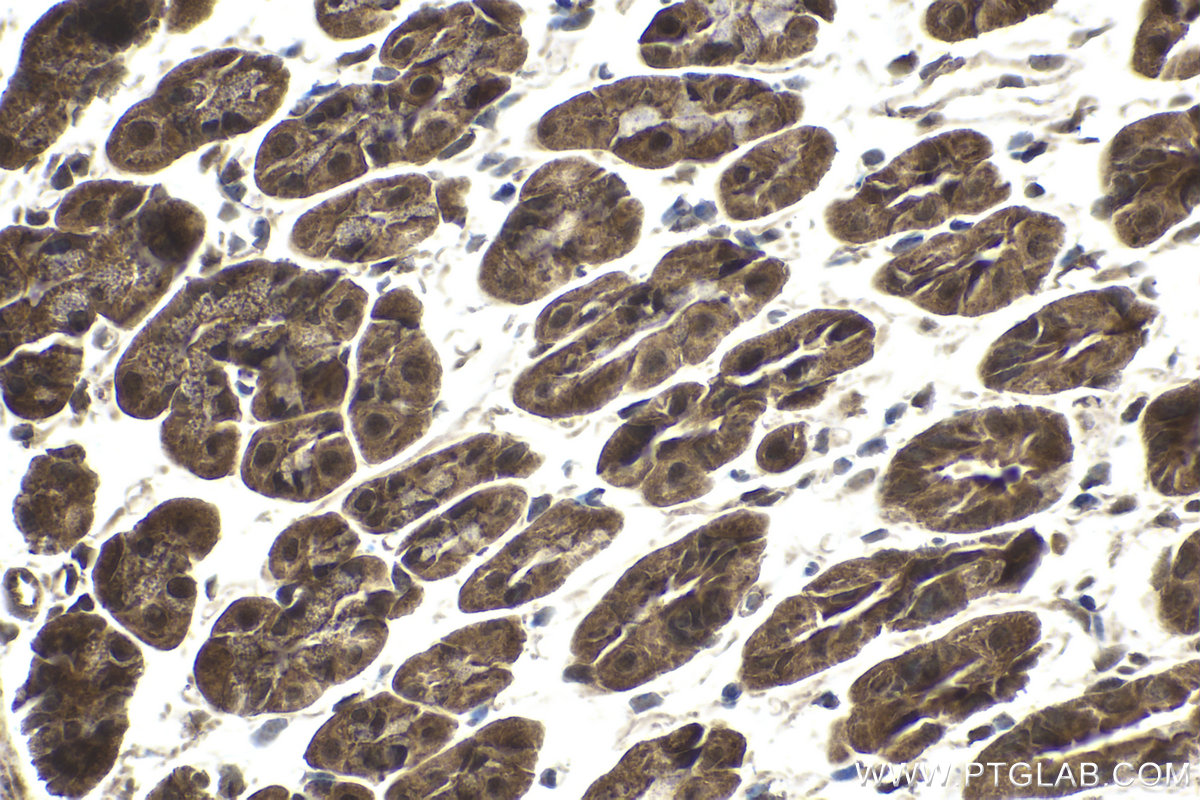

IHCeasy® CARM1 Ready-To-Use IHC Kit
CARM1 Ready-to-use reagent kit for IHC.
Reactivity
Human, Mouse, Rat
Sample Type
FFPE tissue
Cat no : KHC1810
Synonyms
CARM1, PRMT4
Validation Data Gallery
Product Information
KHC1810 is a ready-to-use IHC kit for staining of CARM1. The kit provides all reagents, from antigen retrieval to cover slip mounting, that require little to no diluting or handling prior to use. Simply apply the reagents to your sample slide according to the protocol and you're steps away from obtaining high-quality IHC data.
| Product name | IHCeasy CARM1 Ready-To-Use IHC Kit |
| Sample type | FFPE tissue |
| Assay type | Immunohistochemistry |
| Primary antibody type | Rabbit Polyclonal |
| Secondary antibody type | Polymer-HRP-Goat anti-Rabbit |
| Reactivity | Human, Mouse, Rat |
Kit components
| Component | Size | Concentration |
|---|---|---|
| Antigen Retrieval Buffer | 100 mL | 50× |
| Washing Buffer | 100 mL ×2 | 20× |
| Blocking Buffer | 5 mL | RTU |
| Primary Antibody | 5 mL | RTU |
| Secondary Antibody | 5 mL | RTU |
| Chromogen Component A | 0.2 mL | RTU |
| Chromogen Component B | 4 mL | RTU |
| Signal Enhancer | 5 mL | RTU |
| Counter Staining Reagent | 5 mL | RTU |
| Mounting Media | 5 mL | RTU |
| Datasheet | 1 Copy | |
| Manual | 1 Copy |
Background Information
CARM1, also named as PRMT4, belongs to the protein arginine N-methyltransferase family. It is a dual functional coregulator that facilitates transcription initiation by methylation of Arg17 and Arg26 of histone H3 and also dictates the subsequent coactivator complex disassembly by methylation of the steroid receptor coactivator family coactivators and p300/cAMP-response element-binding protein. CARM1 functions as a coactivator for many nuclear receptors, such as oestrogen receptor, androgen receptor, thyroid receptor and farnesoid X-receptor. It also coactivates other transcription factors such as myocyte enhancer factor 2C (MEF2C), β-catenin, p53, nuclear factor (NF)-kB and the cAMP-responsive element-binding factor. The enzymatic activity and coactivator function of CARM1 has been found to be inactivated through phosphorylation at a conserved serine residue at mitosis stage.
Properties
| Storage Instructions | All the reagents are stored at 2-8°C. The kit is stable for 6 months from the date of receipt. |
| Synonyms | CARM1, PRMT4 |